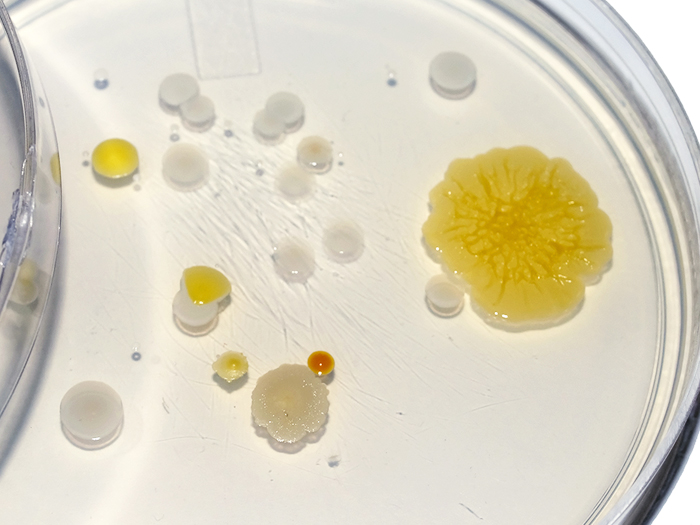

微生物検査とは
微生物検査は、食品中の衛生指標菌や食中毒に係わる食中毒菌など微生物の有無を調べる検査です。
食品の腐敗や変敗、風味や品質の低下は微生物が原因で発生する場合が多く、食中毒の発生を制御して安全な食品を提供するためには、食品取扱事業者による自主的な衛生管理が極めて重要です。
Mérieux NutriSciences Japanでは一般生菌数や大腸菌群等の衛生指標菌をはじめ、黄色ブドウ球菌、サルモネラ等の食中毒菌の検査を受託しています。
食品の保存・安全性など品質の維持管理に活用されています。
推奨検査項目(食品別)
| 一般生菌数 | 大腸菌群 | 大腸菌 | 黄色ブドウ球菌 | 腸炎ビブリオ | サルモネラ | カンピロバクター | ウェルシュ菌 | セレウス菌 | 腸管出血性大腸菌O157 | 乳酸菌 | |
|---|---|---|---|---|---|---|---|---|---|---|---|
| 生鮮魚介類 | ◎ | ○ | ○ | ◎ | |||||||
| 魚肉練り製品 | ◎ | ◎ | ○ | ○ | ○ | ||||||
| 牛肉・豚肉・鶏肉 | ◎ | ◎ | ○ | ○ | ◎ | ○ | △ | ○ | |||
| 食肉製品 | ◎ | ○ | ◎ | ○ | ○ | ||||||
| 卵およびその加工品 | ◎ | ○ | ○ | ◎ | |||||||
| 野菜 | ◎ | ◎ | ○ | ○ | △ | △ | |||||
| 弁当・惣菜・調理パン | ◎ | ◎ | ○ | ◎ | ○ | ○ | ○ | ○ | |||
| 豆腐類 | ◎ | ◎ | ○ | ○ | |||||||
| 牛乳、アイスクリーム等 | ◎ | ◎ | △ | ○ | |||||||
| 生菓子 | ◎ | ◎ | ○ | ◎ | ○ | ○ |
◎:検査を通常実施する項目
○:検査実施が望ましい項目
△:検体によって検査を実施するほうがよい項目
衛生指標菌
中温性好気性菌の総数であり、食品の微生物汚染の度合いを評価する最も重要な指標菌です
環境衛生管理上の汚染指標菌であり、大腸菌だけでなく自然界に広く存在する類似菌も含みます
糞便汚染の指標菌であり、検出された場合は腸管系の病原菌による汚染の可能性が示唆されます
一般的に湿度の高い時期に発生しやすいが、穀類や乾燥食品で繁殖する乾燥に強いカビもいます
環境中に広く存在し、密封した食品に混入すると、発酵して膨張を引き起こす原因となります
芽胞(硬い殻状構造)形成菌で熱や乾燥に強く、穀類、豆類、香辛料、野菜等に多く存在します
食中毒菌
手の傷口に多く存在しており、手作業で食品に直接接触すると食中毒が発生する原因となります
加熱不足の卵・肉・魚料理が原因になりやすく、ペットの糞から感染する場合もあります
加熱不足の肉が原因になりやすく、ベロ毒素を産生して重篤な症状を引き起こします
嘔吐型と下痢型の2つがあり、日本で多い嘔吐型はピラフやスパゲティが原因になりやすいです
生の魚介類(刺身や寿司)が原因になりやすく、夏場に多く発生します
加熱不足の鶏肉や未殺菌の井戸水が原因になりやすく、最も食中毒が発生しやすい菌の一つです
所要日数と料金
検査・分析のご依頼
検査・分析に関するご質問や不明な点などがありましたら、お問い合わせフォームまたはお電話にてお問い合わせください。
